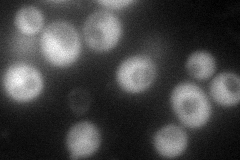
YGL087C
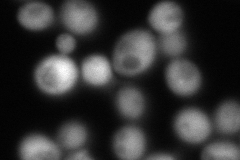
YGL087C
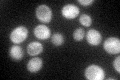
YGL087C

View description
Ubiquitin-conjugating enzyme variant involved in error-free postreplication repair; forms a heteromeric complex with Ubc13p, an active ubiquitin-conjugating enzyme; cooperates with chromatin-associated RING finger proteins, Rad18p and Rad5p
Localization:
Intensity:
Fold change:
Significance:
-
C’ GFP library in SD

cytosol44.06 -
N' NOP1pr-GFP in SD
cytosol107.948 -
N' TEF2pr-mCherry in SD
cytosol189.828 -
N' NATIVEpr-GFP in SD

cytosol28.4568 -
N' TEF2pr-VC and Cyto-VN in SD

#N/A0 -
C’ GFP library in SD+DTT

cytosolN/AN/ANo -
C’ GFP library in SD+H2O2

cytosolN/AN/ANo -
C’ GFP library in Starvation Media
cytosolN/AN/AYes -
C’ GFP library on the background of Pup2-DaMP

cytosol -
C’ GFP library on the background of CCT mutant

cytosolN/AN/ANo
